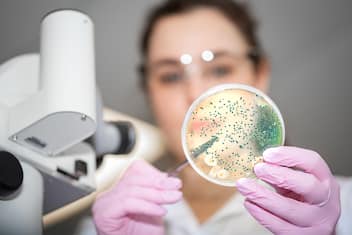

Rischio Listeria, tramezzini ritirati: ecco dove e quale marchio
Salute e Benessere
Si tratta di tramezzini farciti a marchio Ibis, prodotti da Italia Alimentari Spa, richiamato...
)
)
)

)
)
)
)
)
)
)